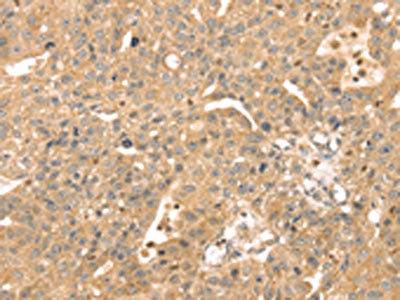

ATOX1 Antibody
-
中文名稱:ATOX1兔多克隆抗體
-
貨號(hào):CSB-PA781114
-
規(guī)格:¥1100
-
圖片:
-
The image on the left is immunohistochemistry of paraffin-embedded Human breast cancer tissue using CSB-PA781114(ATOX1 Antibody) at dilution 1/30, on the right is treated with fusion protein. (Original magnification: ×200)
-
The image on the left is immunohistochemistry of paraffin-embedded Human lung cancer tissue using CSB-PA781114(ATOX1 Antibody) at dilution 1/30, on the right is treated with fusion protein. (Original magnification: ×200)
-
-
其他:
產(chǎn)品詳情
-
Uniprot No.:
-
基因名:ATOX1
-
別名:ATOX1 antibody; ATOX1_HUMAN antibody; ATX1 antibody; ATX1 antioxidant protein 1 homolog (yeast) antibody; ATX1 antioxidant protein 1 homolog antibody; Copper transport protein antibody; Copper transport protein ATOX1 antibody; HAH1 antibody; Metal transport protein antibody; Metal transport protein ATX1 antibody; MGC138453 antibody; MGC138455 antibody
-
宿主:Rabbit
-
反應(yīng)種屬:Human,Mouse,Rat
-
免疫原:Fusion protein of Human ATOX1
-
免疫原種屬:Homo sapiens (Human)
-
標(biāo)記方式:Non-conjugated
-
抗體亞型:IgG
-
純化方式:Antigen affinity purification
-
濃度:It differs from different batches. Please contact us to confirm it.
-
保存緩沖液:-20°C, pH7.4 PBS, 0.05% NaN3, 40% Glycerol
-
產(chǎn)品提供形式:Liquid
-
應(yīng)用范圍:ELISA,IHC
-
推薦稀釋比:
Application Recommended Dilution ELISA 1:2000-1:5000 IHC 1:25-1:100 -
Protocols:
-
儲(chǔ)存條件:Upon receipt, store at -20°C or -80°C. Avoid repeated freeze.
-
貨期:Basically, we can dispatch the products out in 1-3 working days after receiving your orders. Delivery time maybe differs from different purchasing way or location, please kindly consult your local distributors for specific delivery time.
-
用途:For Research Use Only. Not for use in diagnostic or therapeutic procedures.
相關(guān)產(chǎn)品
靶點(diǎn)詳情
-
功能:Binds and deliver cytosolic copper to the copper ATPase proteins. May be important in cellular antioxidant defense.
-
基因功能參考文獻(xiàn):
- Copper chaperone Atox-1 is involved in the induction of SOD3 in a monocyte cell line. PMID: 29168020
- Since full occupancy of the tetrahedral cavity is a common feature of all Atox1 dimeric structures obtained with other metal ions (Cu(+), Cd(2+), and Hg(2+)), we propose that in the case of platinum, where the occupancy is only 0.4, the remaining cavities are occupied by Cu(+) ions PMID: 27305454
- Data suggest that N-terminal segment of metal-binding domains (MBDs) 1-3 of ATOX1 interact with nucleotide-binding domain of ATP7B, thus physically coupling the domains involved in copper binding and those involved in ATP hydrolysis; interactions with MBDs 1-3 of ATOX1 activate ATP7B ATP hydrolysis. (ATOX1 = copper transport protein ATOX1; ATP7B = Cu-binding P type ATPase ATP7B) PMID: 28900031
- It show that copper(I) and glutathione form large polymers with a molecular mass of approximately 8 kDa, which can transfer copper to Atox1. PMID: 28549213
- Highlighted in this review are unique redox properties of Atox1 and other copper chaperones. Also, summarized are the redox nodes in the cytosol which potentially play dominant roles in the redox regulation of copper chaperones PMID: 28294521
- The structural flexibility of the human copper chaperone Atox1 has been reported based on insights from combined pulsed EPR studies and computations. PMID: 28543811
- Cu chaperone Atox1 has a role in breast cancer cell migration PMID: 28027931
- Multiple genetic models identified genetic associations with systolic blood pressure and ATOX1. PMID: 26866891
- In addition to Atox1, the human cytoplasm also contains Cu chaperones for loading of superoxide dismutase 1 (i.e. CCS) and cytochrome c oxidase in mitochondria (i.e. Cox17). [review] PMID: 26745464
- results suggest the possibility of a therapy with copper-chelating or ionophore drugs in subtypes of tumors showing specific alterations in ATOX1 expression PMID: 26784148
- C-Terminus of Human Copper Importer Ctr1 Acts as a Binding Site and Transfers Copper to Atox1 PMID: 26745413
- Cu chaperone function of Atox1 mediated through Cu transporter ATP7A is required for VEGF-induced angiogenesis via activation of Cu enzyme lysyl oxidase. PMID: 26437801
- Upon neuronal differentiation, transitions in redox states upregulates expression of ATOX1 and its partner ATP7A, producing higher flux of copper through the secretory pathway. PMID: 26879543
- To identify new interactions partners of Atox1, a yeast two-hybrid screen with a large human placenta library of cDNA fragments using Atox1 as bait, was performed. PMID: 26213915
- Studied the localization of Atox1 in HeLa cells using fluorescence imaging in combination with in vitro binding experiments to fluorescently labeled DNA duplexes harboring the proposed promotor sequence. PMID: 25962064
- Human cytoplasmic copper chaperones Atox1 and CCS exchange copper ions in vitro PMID: 25673218
- Cisplatin is one of the most used anticancer drugs. Its cellular influx and delivery to target DNA may involve the copper chaperone Atox1 protein. PMID: 25111319
- The data collected here shows that the Atox1 keeps its dimer nature also in the presence of the CTR1 c-terminal domain; however, two geometrical states are assumed by the Atox1. PMID: 24837030
- The Cu-binding motif in Atox1, as well as in target Cu-binding domains of ATP7A/B, consists of a MX1CXXC motif where X1 = T. PMID: 24824562
- Human Grx1 can catalyse reduction of Atox1 by glutathione but only in the presence of Cu(I). PMID: 24522867
- These results indicate that the roles of Atox1 in the regulation of cellular trafficking of platinum drugs are dependent on the coordination configurations. PMID: 24469739
- Atox1 has a role in copper transport to tumor cell nuclei. PMID: 24445997
- CTR1 silencing increased the protein levels of copper chaperone ATOX1 and copper chaperone for superoxide dismutase 1 (CCS-1), but decreased copper chaperone for cytochrome c oxidase (COX17). PMID: 24343031
- Atox1 contains positive residues that mediate membrane association and aid subsequent copper loading. PMID: 24036897
- the primary coordination site of Atox1 for interaction wtih cisplatin is at the cysteine residues in the Cu(I)-binding sequence Cys(12)GlyGlyCys(15) PMID: 23778981
- Based on structural analysis, this work determines that the protein possesses two distinct conformations referred to as "in" and "out" due to the relative positioning of Cys12 (one of Cu(I) binding residues). PMID: 23553875
- Knockdown of ATOX1 in non-small cell lung cancer cells was associated with reduction in copper-stimulated cell proliferation. These findings suggest that ATOX1 plays an important role in copper-stimulated proliferation of non-small cell lung cancer cells. PMID: 23624903
- Binding of free cisplatin and reaction with the cisplatin-loaded Atox1 produce the same protein-bound platinum intermediate in the transfer of metal-binding domain (repeat) (MBD)2 from Atox1. PMID: 23751120
- different effects of ATX1 unfolding on Cu(I) affinity PMID: 23169585
- GSSG oxidizes copper-coordinating cysteines of Atox1 with formation of an intramolecular disulfide. GSH alone is sufficient to reduce the disulfide, restoring the ability of Atox1 to bind copper; glutaredoxin 1 facilitates this reaction when GSH is low PMID: 22648419
- No major role can be attributed to Atox1 and COMMD in the pathophysiology or clinical variation of Wilson disease. PMID: 22677543
- thermodynamic parameters of copper (Cu) transfer from the human copper chaperone Atox1 to the fourth metal-binding domain of the Wilson disease protein PMID: 22574136
- By binding to Atox1 in the cytoplasm, cisPt transport to DNA may be blocked. In agreement with this model, cell line studies demonstrate a correlation between Atox1 expression levels, and cisplatin resistance. PMID: 21482801
- Unification of the copper(I) binding affinities of the metallo-chaperones Atx1, Atox1, and related proteins: detection probes and affinity standards. PMID: 21258123
- transfers copper to the NH2-terminal domain of the Wilson's disease protein and regulates its catalytic activity PMID: 12029094
- Gene structure of ATOX1. PMID: 12594858
- A copper-dependent interaction of Atox1 with the metal binding sites of menkes protein was observed PMID: 12679332
- X-ray absorption spectroscopy of this copper chaperone reveals a copper center capable of formation with exogenous thiols and phosphines PMID: 12686548
- Regulates the function of ATP7B in Wilson's disease PMID: 12763797
- handling of copper by Atox1 and copper transfer between Atox1 and WND are under kinetic rather than thermodynamic control PMID: 14709553
- Detailed structural and dynamic characterization of the behavior of human HAH1 in solution, in the physiologically relevant reduced apo and copper(I)-bound forms PMID: 15476398
- interaction between the human copper(I) chaperone, HAH1, and one of its two physiological partners, the Menkes disease protein (ATP7A), was investigated in solution using heteronuclear NMR PMID: 15670166
- Atox1 functions not only as a copper chaperone for SOD3 but also as a positive regulator for SOD3 transcription and may have an important role in modulating oxidative stress in the cardiovascular system. PMID: 15761197
- a three-domain construct of ATP7A interacts with copper(I) and copper(I)-HAH1 PMID: 16172131
- Wilson disease protein is an acceptor of oopper from HAH1 protein. PMID: 16571664
- localization of ATP7A between the trans-Golgi network and the plasma membrane may be regulated by the accumulation of the adducts with HAH1, whereas the main role of domains 5 and 6 is to assist copper(I) translocation PMID: 17545667
- The results from the quantum mechanical (QM) and MD simulations suggest that either a two- or three-coordinate exchange reaction is preferred and that it is unlikely that a four-coordinate Cu(I) species plays a role in copper exchange. PMID: 17616150
- Divergent energetic properties of Atox1 apo- and holo-forms may be linked to conformational changes that facilitate copper transfer to the target. PMID: 17881304
- Atox1 functions as a novel transcription factor that, when activated by copper, undergoes nuclear translocation, DNA binding, and transactivation, thereby contributing to cell proliferation. PMID: 18245776
- No major role can be attributed to Atox1 in the pathophysiology or clinical variation of Wilson disease. PMID: 18416466
顯示更多
收起更多
-
蛋白家族:ATX1 family
-
組織特異性:Ubiquitous.
-
數(shù)據(jù)庫鏈接:
Most popular with customers
-
-
YWHAB Recombinant Monoclonal Antibody
Applications: ELISA, WB, IHC, IF, FC
Species Reactivity: Human, Mouse, Rat
-
Phospho-YAP1 (S127) Recombinant Monoclonal Antibody
Applications: ELISA, WB, IHC
Species Reactivity: Human
-
-
-
-
-